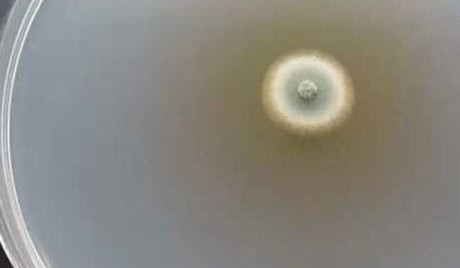
Lộ ảnh chụp manh mối vụ thực phẩm chức năng của Nhật liên quan 5 người tử vong

Ban đầu, Kobayashi cho biết có 5 người đã tử vong sau khi dùng thực phẩm chức năng chứa men gạo đỏ giúp kiểm soát cholesterol. Sau đó, hãng dược điều chỉnh con số thành 4 vì một người tử vong không dùng sản phẩm trên.
Ngày 28/6, Kobayashi công bố họ đang xem xét tiếp 76 trường hợp tử vong liên quan tới thực phẩm chức năng của hãng.

Bộ Y tế Nhật cho biết gia đình những người đã mất liên hệ với Kobayashi và Bộ sẽ tiến hành phân tích sâu hơn.
Ngoài ra, Bộ Y tế Nhật bày tỏ sự không hài lòng về tốc độ thông tin của Kobayashi sau khi vụ bê bối xảy ra vào tháng 3. Bộ trưởng Y tế Keizo Takemi cho hay: “Thật vô cùng đáng tiếc. Việc điều tra các trường hợp tử vong không thể giao cho Kobayashi. Bộ Y tế sẽ trực tiếp quản lý".
Công ty có trụ sở tại Osaka cho biết lý do khiến số ca tử vong có thể liên quan đến thực phẩm chức năng tăng lên đáng kể là do họ tốn thời gian để tìm mối liên hệ giữa các bất ổn sức khỏe với việc tiêu thụ sản phẩm của mình.
Trong số 76 trường hợp mới, nguyên nhân tử vong không chỉ bao gồm các bệnh liên quan đến thận mà còn có ung thư, nhồi máu não, viêm phổi và bóc tách động mạch chủ.
Theo CBS, Bộ Y tế Nhật từng yêu cầu Kobayashi nộp báo cáo hằng ngày về cuộc điều tra và yêu cầu thêm thông tin chi tiết vào đầu tháng này về số người tử vong. Hãng dược cho biết các gia đình đã liên hệ với công ty về cái chết của 170 người. Sau đó, họ xác nhận, 94 người không dùng thực phẩm chức năng.
Bộ Y tế đề nghị Kobayashi phải lập báo cáo về cách thức điều tra và nguyên nhân có thể dẫn đến 76 trường hợp tử vong.
Ngày 28/6, Kobayashi lần nữa gửi lời xin lỗi: "Chúng tôi đã khiến công chúng rất lo lắng”. Đáp lại bình luận của Bộ trưởng Y tế, hãng dược cho biết: "Chúng tôi rất coi trọng vấn đề này”.
Trước đó, ngày 22/3, Kobayashi công bố một số người đã mắc các bệnh liên quan tới thận sau khi sử dụng thực phẩm chức năng nhằm giảm mức cholesterol LDL, được gọi là cholesterol "xấu". Họ đã thu hồi ba sản phẩm chứa gạo men đỏ.
Công ty cho biết họ phát hiện axit puberulic, một hợp chất tự nhiên sinh ra nấm mốc xanh, trong các thành phần được dùng để sản xuất thực phẩm chức năng. Hợp chất này có thể là nguyên nhân gây ra bệnh tật.
Kobayashi là hãng dược quen thuộc ở Nhật Bản, cung cấp nhiều loại sản phẩm liên quan đến sức khỏe. Công ty đã phân phối gạo men đỏ cho khoảng 50 đơn vị khác ở Nhật và 2 đơn vị ở Đài Loan. Sau khi vụ bê bối xảy ra, Đài Loan đã thu hồi 154 sản phẩm chứa gạo men đỏ.

Hãng dược lên tiếng về vụ thực phẩm chức năng của Nhật liên quan 5 ca tử vong
